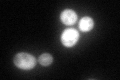
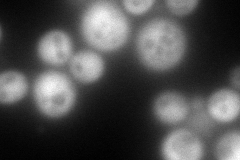
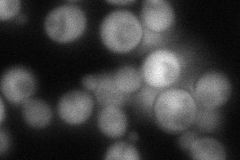
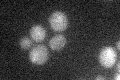

View description
S-adenosylmethionine-homocysteine methyltransferase, functions along with Mht1p in the conversion of S-adenosylmethionine (AdoMet) to methionine to control the methionine/AdoMet ratio
Localization:
Intensity:
Fold change:
Significance:
-
C’ GFP library in SD
cytosol97.02 -
N' NOP1pr-GFP in SD
cytosol297.806 -
N' TEF2pr-mCherry in SD

cytosol361.959 -
N' NATIVEpr-GFP in SD
cytosol73.4911 -
N' TEF2pr-VC and Cyto-VN in SD

cytosol83.5178 -
C’ GFP library in SD+DTT

cytosol47.610.49Yes -
C’ GFP library in SD+H2O2

cytosol123.831.27No -
C’ GFP library in Starvation Media
cytosol23.680.24No -
C’ GFP library on the background of Pup2-DaMP

cytosol -
C’ GFP library on the background of CCT mutant

cytosol92.23770.950645No
